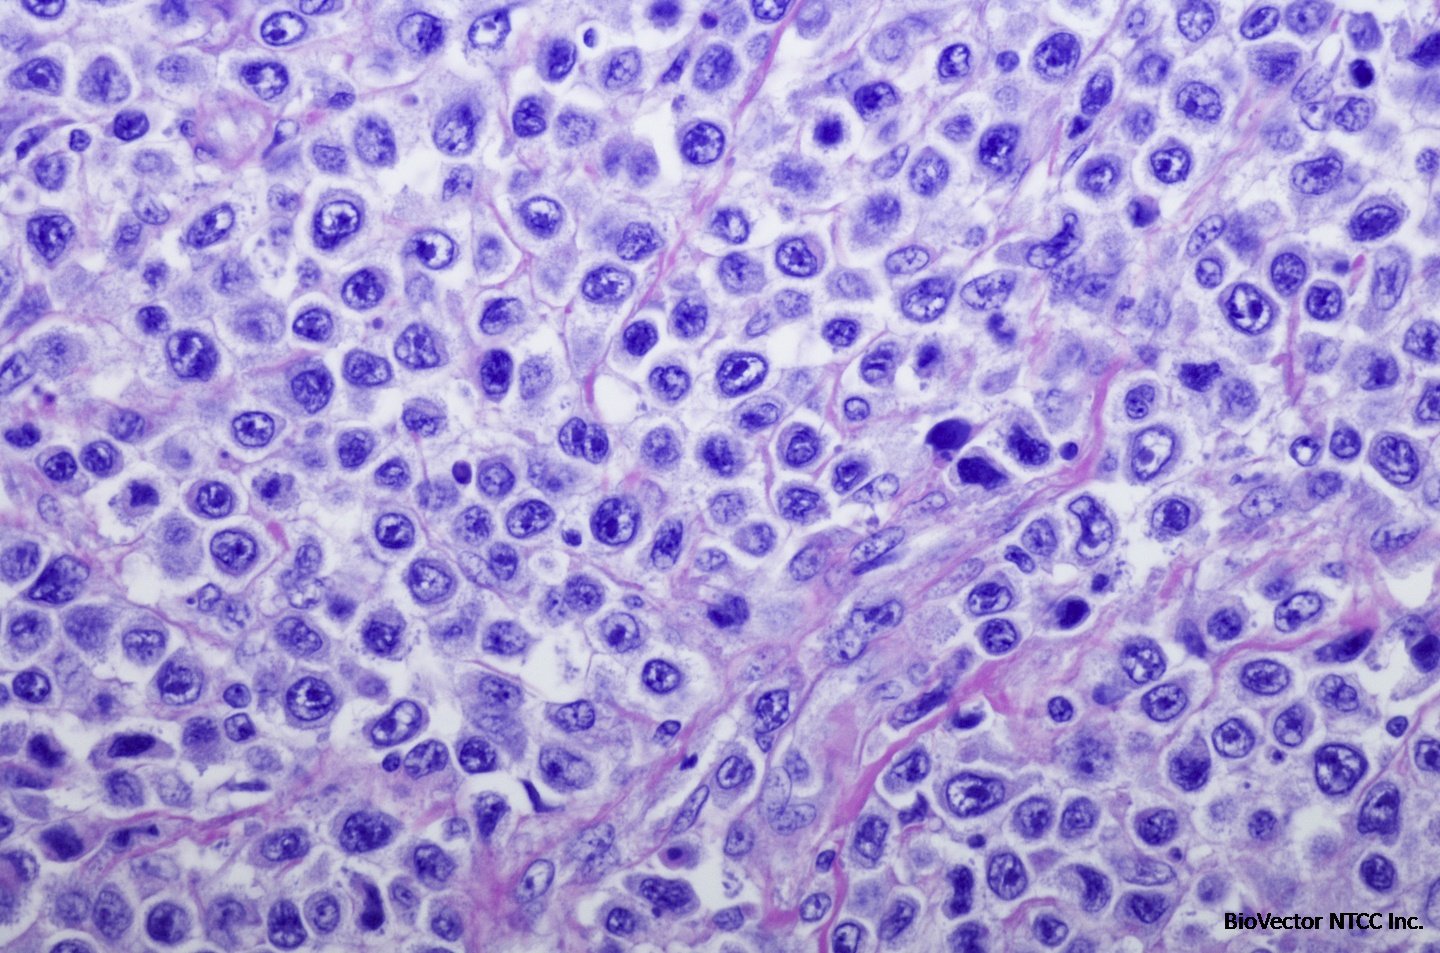
Diffuse Large B-Cell Lymphoma – Karyopharm Therapeutics

K231 BioVector®人弥漫大B细胞淋巴瘤细胞系 / Human Diffuse Large B-cell Lymphoma Cell Line
- 价 格:¥99850
- 货 号:BioVector®-K231
- 产 地:北京
- BioVector NTCC典型培养物保藏中心
- 联系人:Dr.Xu, Biovector NTCC Inc.
电话:400-800-2947 工作微信:1843439339 (QQ同号)
邮件:Biovector@163.com
手机:18901268599
地址:北京
- 已注册
BioVector® K231 人弥漫大B细胞淋巴瘤细胞系 / Human Diffuse Large B-cell Lymphoma Cell Line 数据说明书
产品名称: BioVector® K231 细胞
同义词: BioVector® KARPAS231; BioVector® KARPAS-231; BioVector® K-231
中文名称: BioVector® K231 人弥漫性大B细胞淋巴瘤细胞系
英文名称: BioVector® K231 Human Diffuse Large B-cell Lymphoma Cell Line
产品类别: 血液肿瘤细胞系
物种来源: 人 (Homo sapiens)
组织来源: 外周血
疾病: 弥漫性大B细胞淋巴瘤 (DLBCL)
患者信息: 71岁女性
形态特性: 悬浮生长,淋巴母细胞样
生长特性: 悬浮生长
构建方法: 从弥漫性大B细胞淋巴瘤患者的外周血样本中建立
特性特征:
染色体易位: 携带 t(14;18)(q32;q21) 和 t(3;11)(q27;q23.1) 易位
EB病毒状态: 未报道,通常DLBCL细胞系多为EBV阴性
基因表达特征: 与OCI-LY8等其他DLBCL细胞系相比,K231细胞系中miR-28表达水平较高;BCL-6和LPP蛋白表达水平较低
bcl-6基因状态: 由于未涉及Ig基因的易位,bcl-6 mRNA在该细胞系中未见表达
研究应用: 弥漫性大B细胞淋巴瘤(DLBCL)的生物学特性研究、基因表达调控研究、药物筛选的重要体外模型
培养基: BioVector® K231 细胞专用完全培养基(推荐基础成分:RPMI-1640培养基,添加10-20%胎牛血清和1%青霉素-链霉素)
培养条件: 气相:95%空气,5%二氧化碳;温度:37°C
传代方法: 维持细胞密度在2×10⁵ - 1×10⁶ cells/mL之间,每2-3天传代或更换新鲜培养基
冻存液: BioVector® 细胞冻存液(推荐配方:90%胎牛血清 + 10% DMSO)
质控载体: BioVector® pUC19 质粒
宿主菌: BioVector® DH5α 化学感受态细胞
质量控制: 支原体检测:阴性;无菌检测:阴性;STR分型:已验证(参考KARPAS231)
储存与运输: 液氮或干冰运输与保存(-150°C至-190°C)
生物安全等级: 1(需在二级生物安全柜内操作)
仅供科研使用
English:
BioVector® K231 Human Diffuse Large B-cell Lymphoma Cell Line Datasheet
Product Name: BioVector® K231 Cells
Synonyms: BioVector® KARPAS231; BioVector® KARPAS-231; BioVector® K-231
Chinese Name: BioVector® K231 人弥漫性大B细胞淋巴瘤细胞系
English Name: BioVector® K231 Human Diffuse Large B-cell Lymphoma Cell Line
Product Category: Hematologic Cancer Cell Line
Species of Origin: Human (Homo sapiens)
Tissue of Origin: Peripheral blood
Disease: Diffuse Large B-cell Lymphoma (DLBCL)
Patient Information: 71-year-old female
Morphology: Suspension growth, lymphoblast-like
Growth Characteristics: Suspension
Derivation: Established from peripheral blood sample of a patient with Diffuse Large B-cell Lymphoma
Characteristics:
Chromosomal Translocations: Carries t(14;18)(q32;q21) and t(3;11)(q27;q23.1) translocations
EBV Status: Not reported; typically DLBCL cell lines are EBV negative
Gene Expression Profile: Compared to other DLBCL cell lines such as OCI-LY8, K231 cells show relatively high miR-28 expression levels and low BCL-6 and LPP protein expression levels
bcl-6 Gene Status: Due to the absence of Ig gene involvement in translocations, bcl-6 mRNA expression is not detected in this cell line
Research Applications: Important in vitro model for studying DLBCL biology, gene expression regulation, and drug screening
Culture Medium: BioVector® Complete Medium for K231 Cells (Recommended composition: RPMI-1640 medium supplemented with 10-20% fetal bovine serum and 1% penicillin-streptomycin)
Culture Conditions: Atmosphere: 95% air, 5% CO₂; Temperature: 37°C
Subculturing Method: Maintain cell density between 2×10⁵ - 1×10⁶ cells/mL; subculture or replenish with fresh medium every 2-3 days
Freeze Medium: BioVector® Cell Freeze Medium (Recommended composition: 90% FBS + 10% DMSO)
Control Vector: BioVector® pUC19 Plasmid
Host Strain: BioVector® DH5α Chemically Competent Cells
Quality Control: Mycoplasma: Negative; Sterility: Negative; STR Profiling: Authenticated (as KARPAS231)
Storage and Shipment: Stored and shipped in liquid nitrogen or on dry ice (-150°C to -190°C)
Biosafety Level: 1 (Operate in a Class II biological safety cabinet)
For Research Use Only
BioVector NTCC质粒载体菌株细胞蛋白抗体基因保藏中心
电话:400-800-2947
工作QQ/微信同号:1843439339
网址
- 公告/新闻




